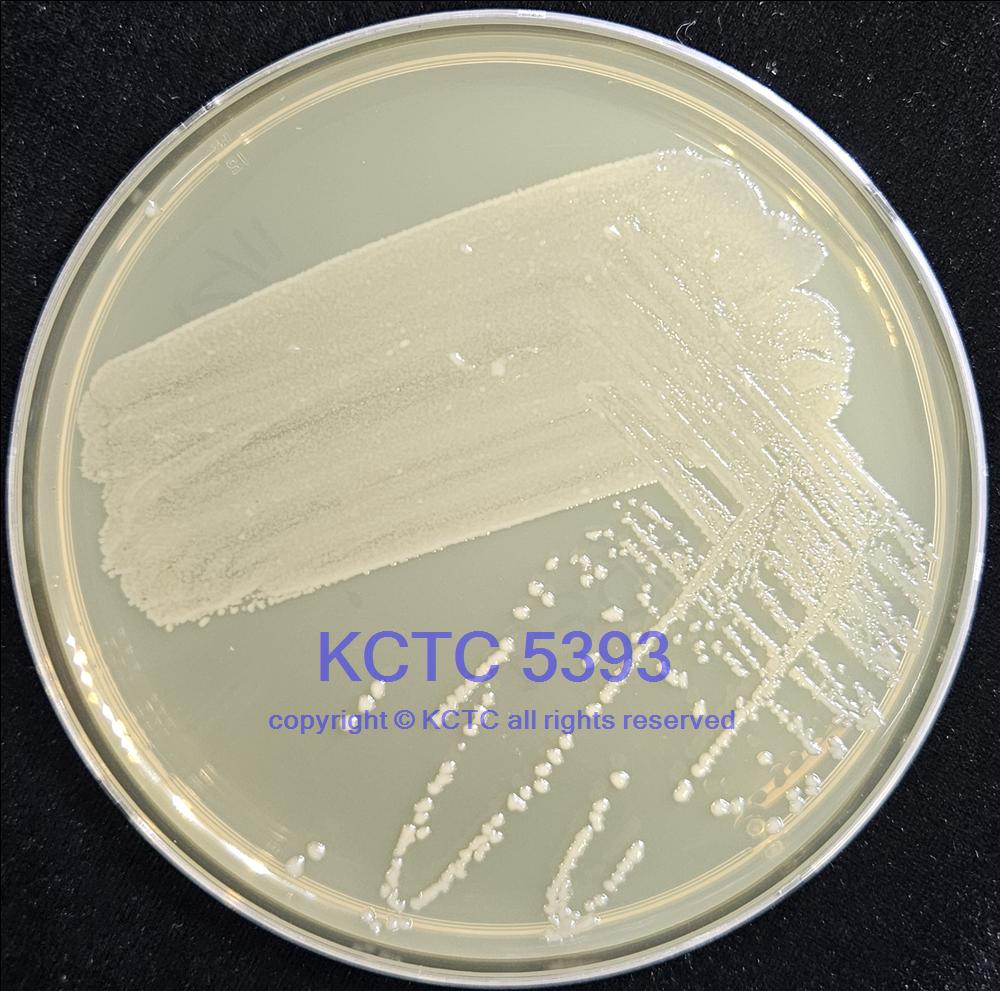

KCTC No. 5393
(KCTC Other No.)
Resource Type Bacteria
Name Paraclostridium bifermentans subsp. bifermentans
Type Strain Yes
Biosafty Level 2
LMO No
Synonym Clostridium bifermentans, "Bacillus bifermentans"
Phylum (ex Phylum) Bacillota (Firmicutes)
Genome Information
NCBI Genome UID : GCA_019916025.1
History <- CIP <- JP Carlier, Inst. Pasteur, Paris, France, strain 10028 <- ATCC <- IC Hall, strain 76, Bacillus
Source From soil
Other Collection No. 76, Hall 76, ATCC [638], BCRC [14542], BCRC [14542], CCUG [36626], CIP [104309], DSM [14991], JCM [1386], NCIMB [10716], NCTC [13019]
Reference 1 / 10.1099/ijs.0.63578-0, 10.1099/ijsem.0.000874
KCTC Media No. KCTC media No. 8 Reinforced Clostridial Medium
Oxygen Requirement Anaerobic
Temperature 37 ℃
pH netural pH ?? ?? (???? ??)
Incubation Time 2-3 d [???? ???? ????? ??, ?? ? ????? ??? ?? ?? ? ??]